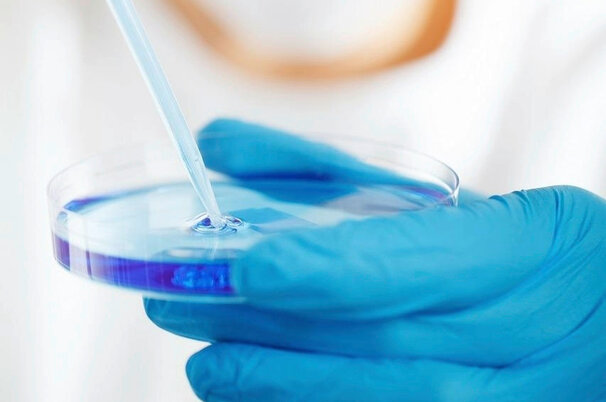

Artikel werden durchsucht.
Regionen
Westschweiz
Waadt darf Wolfsrudel vollständig abschiessen
Vermischtes
Ausbildungen
Schnupperlehre hat grossen Einfluss auf Berufswahl
Politik & Wirtschaft
Agrarwirtschaft
Landesversorgung: Erneut Wechsel an der Spitze
Regionen
Ostschweiz
«Ich will Lebensmittel produzieren»
Vermischtes
Allerlei
Post: Abbau wird durchgezogen
Tiere
Pferde
Über 500 Freiberger erwartet
Politik & Wirtschaft
Betriebsführung
Auf Vertrauen setzen
Politik & Wirtschaft
Agrarpolitik
Wie vereinfachen andere Staaten ihre Agrarpolitik?
Vermischtes
Allerlei
Vogelgrippe-Fall bei Person gibt Rätsel auf
Vermischtes
Bild der Woche
Sieg für Blütentraum aus Pink und Lila
Das Wetter heute in
Lesershop
Umfrage

Sollen alle Nutztiere gesetzlichen Anspruch auf Auslauf im Freien haben?
- Ja, wenn betrieblich möglich:36.81%
- Nein:62.09%
- Bin mir noch unsicher:1.1%
- Halte keine Nutztiere:0%
Teilnehmer insgesamt: 1092
Bekanntschaften
Suchen Sie Kollegen und Kolleginnen für Freizeit und Hobbies? Oder eine Lebenspartnerin oder einen Lebenspartner?